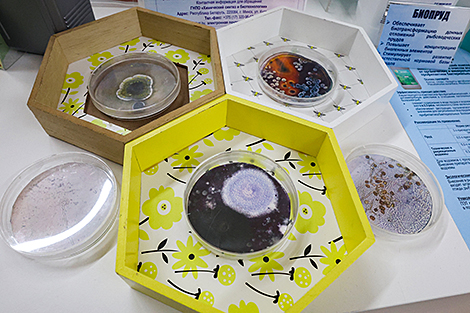

10 декабря, Минск /Корр. БЕЛТА/. Белорусские ученые разработали препарат для повышения урожайности сахарной свеклы. Об этом сообщил журналистам директор Института микробиологии Национальной академии наук Беларуси Александр Шепшелев, передает корреспондент БЕЛТА.
"Из того, что разработано в этом году, можно назвать препарат для сахарной свеклы, который приводит к повышению урожайности, повышению эффективности выращивания свеклы и нивелированию влияния негативных факторов окружающей среды на продуктивность сортов. Данный препарат подготовлен совместно с профильным институтом сельскохозяйственной отрасли - РУП "Опытная научная станция по сахарной свекле", - рассказал Александр Шепшелев.

Он также назвал основные направления работы в области микробных удобрений. "Это повышение урожайности за счет вовлечения в метаболизм растений фосфора, который находится в неусваиваемой форме в почве. Микроорганизмы позволяют его усваивать. А также использование азотфиксирующих микроорганизмов, которые позволяют связывать азот, в том числе из воздуха, и тем самым тоже способствовать росту растений. Кроме всего прочего, микроорганизмы, входя в симбиоз с растением, вырабатывают целый спектр гормонов, которые способствуют снижению негативных влияний факторов окружающей среды - заморозков, засух и так далее. Вот именно на этих вещах и базируется применение наших технологий", - отметил директор института.
Ученые постоянно работают над усовершенствованием препаратов. "Понимаем, что конкуренция на рынке достаточно большая. Чтобы оставаться востребованным, необходимо постоянно искать возможности для улучшения. В частности, закваски для силосования, которые 10 лет назад мы разрабатывали и которые есть сейчас, хоть и имеют одно и то же название, но в них заложены уже новые решения, новые, более эффективные составы. И это позволяет и ускорить их работу, и повысить эффективность, и улучшить их хранение", - обратил внимание Александр Шепшелев.